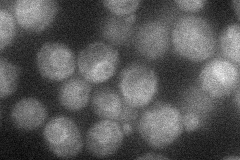
YGR036C
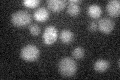
YGR036C

View description
Dolichyl pyrophosphate (Dol-P-P) phosphatase with a luminally oriented active site in the ER, cleaves the anhydride linkage in Dol-P-P, required for Dol-P-P-linked oligosaccharide intermediate synthesis and protein N-glycosylation
Localization:
Intensity:
Fold change:
Significance:
-
C’ GFP library in SD

ER28.04 -
N' NOP1pr-GFP in SD
ER26.3025 -
N' TEF2pr-mCherry in SD

ER,vacuole22.6973 -
N' NATIVEpr-GFP in SD

cytosol35.8548 -
N' TEF2pr-VC and Cyto-VN in SD

below threshold22.8148 -
C’ GFP library in SD+DTT

ER270.96No -
C’ GFP library in SD+H2O2

ER20.260.72Yes -
C’ GFP library in Starvation Media
ER24.770.88No -
C’ GFP library on the background of Pup2-DaMP

ER -
C’ GFP library on the background of CCT mutant

ER22.80660.813092No
